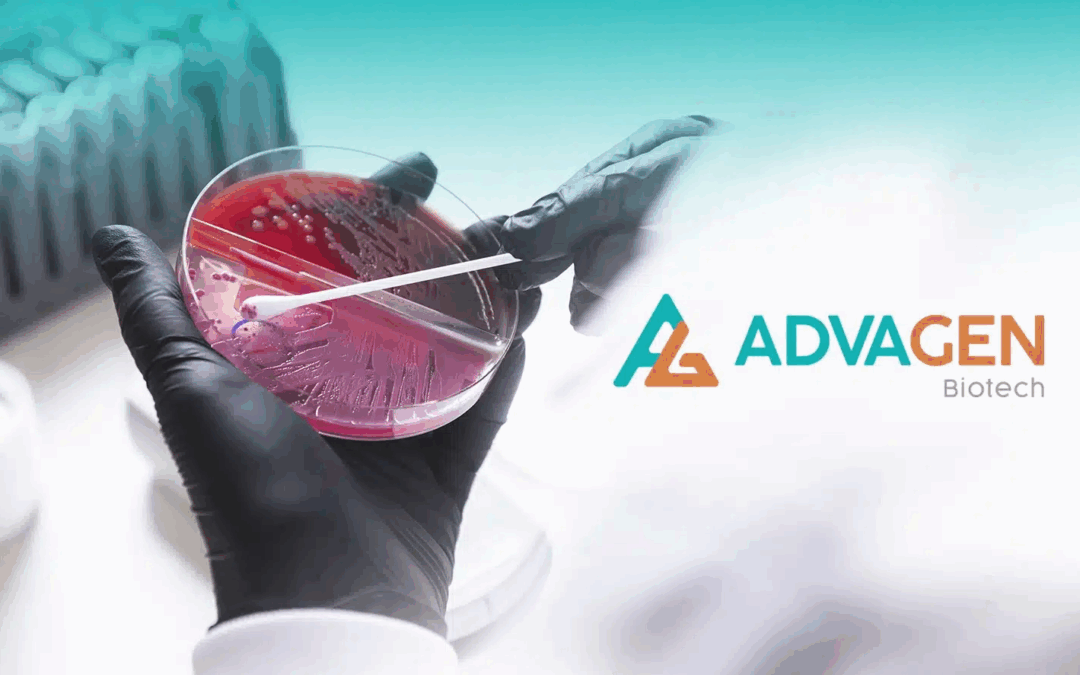
Advagen Biotech leva soluções inovadoras em diagnóstico para a maior feira de saúde da América Latina

Marca brasileira e equipamentos de última geração da Wiener lab estarão na Hospitalar 2025
A Wiener lab, associada à CBDL e primeira fábrica de diagnóstico in vitro (IVD) da América Latina, com sede em Rosário, na Argentina, participa da feira Hospitalar, que acontece de 20 a 23 de maio, das 11 às 20h, no São Paulo Expo, em São Paulo, com a divulgação da...
Advagen Biotech leva soluções inovadoras em diagnóstico para a maior feira de saúde da América Latina
A Advagen Biotech, especializada em microbiologia, integrante do Grupo Bio e associada à CBDL, estará presente na Hospitalar 2025, maior feira de saúde da América Latina, que acontece de 20 a 23 de maio no São Paulo Expo, em São Paulo (SP). A empresa, que compartilha...

Anvisa autoriza produção de etanol farmacêutico em 604 farmácias. Medida busca ampliar tratamento contra intoxicações por bebidas adulteradas
O aumento dos casos de intoxicação por bebidas adulteradas levou autoridades de diferentes estados a intensificar ações de combate. Até o momento, são 217 casos investigados em 14 estados, com 14 confirmações e 12 mortes relacionadas. Diante desse cenário, o governo...

Projeto de Lei sobre Inteligência Artificial na Saúde será coordenado pelo Instituto Ética Saúde
O Instituto Ética Saúde e a Frente Parlamentar Mista da Saúde (FPMS) promoveram, no dia 7 de maio, o evento ‘LGPD, Ética e Inteligência Artificial na Saúde’, na Câmara dos Deputados, em Brasília. Com sala lotada, foram discutidas as necessidades e limites para...

Avaliação de Tecnologia da Saúde em destaque em evento da CBDL e do Einstein
A pesquisadora do Instituto de Saúde da Secretaria da Saúde de São Paulo, Fotini Toscas, membro titular da CONITEC (Comissão Nacional de Incorporação de Tecnologias no Sistema Único de Saúde) conferiu uma palestra sobre o tema da Avaliação de Tecnologia da Saúde (ATS)...
CBDL apoiou seminário sobre desafios da Saúde Suplementar promovido pelo Grupo Fleury e Sindhosp
Aconteceu nesta terça-feira, 27 de junho, em São Paulo, a 10ª edição do seminário que discute a Saúde Suplementar brasileira. Promovido pelo Grupo Fleury e pelo Sindicato dos Hospitais, Clínicas e Laboratórios do Estado de São Paulo (Sindhosp), representantes da...
Roche investe pesado no segmento clínico e laboratorial de coagulação
O mercado clínico e laboratorial de coagulação está ganhando um novo reforço da empresa Roche. A meta da companhia é trabalhar o lançamento da “cobas t”, nova família de sistemas. A Roche produz atualmente soluções Point Of Care (POC) e Multiplate (equipamento...
Novo sistema da Roche libera resultado de hemoglobina glicada em 7,2 segundos
A 7° Edição do Atlas de Diabetes da Federação Internacional da Diabetes (IDF) aponta que em 2025, o Brasil terá uma população de 17,6 milhões de pessoas com diabetes entre as faixas etárias de 20 a 79 anos, e passará a ocupar o quarto lugar entre os países do mundo...
Anvisa institui força-tarefa que fará liberação remota de cargas em SP
Diante do aumento crescente da demanda para análise dos processos de importação nos postos da Coordenação de Vigilância Sanitária de Portos, Aeroportos, Fronteiras e Recintos Alfandegados de São Paulo (CVPAF/SP), em particular, Guarulhos e Congonhas, a Anvisa...
No portal da Anvisa, novo serviço permite acompanhar processos por email
Já está disponível no portal da Anvisa um serviço que permite às empresas e demais usuários acompanhar o andamento dos processos de registro e autorização. A principal novidade é a possibilidade de receber e-mail sempre que o processo passar por alguma tramitação na...
Atrasos em portos e aeroportos e suas consequências é tema de artigo do presidente-executivo da CBDL
De autoria do presidente-executivo da CBDL, Carlos Eduardo Gouvêa, artigo revela que o impacto dos atuais processos aduaneiros nacionais no mercado de saúde foi estimado em R$ 660,50 milhões de prejuízo em 2016. Os custos referem-se à armazenagem, carregamento e...
Taxas de BPF de associados da CBDL serão devolvidas até final de julho
A Câmara Brasileira de Diagnóstico Laboratorial (CBDL) esteve representada, no último dia 11 de maio, em reunião entre o agente regulador e o setor regulado, convocada pela Anvisa. Chamada de “DR” pelo seu presidente, Dr. Jarbas Barborsa, esses encontros...
Gerências da Anvisa apresentam minuta de proposta da RDC 86/16
Em reunião ocorrida na parte da manhã do dia 11 de maio na Anvisa, em Brasília, a GGCIP/GEDOC apresentaram a minuta da proposta de alteração da RDC 86/2016, com as contribuições de 38 associações em Consulta Dirigida realizada em abril deste ano. Muitos...
Anvisa apresenta novo portal de informações analíticas ao setor regulado
Ainda durante a reunião do dia 11 de maio, o Dr. Jarbas Barbosa fez uma apresentação sobre outras demandas de encontros anteriores e providências tomadas pela Anvisa. Informou que o objetivo é ter no Portal Anvisa a solução para todas as dúvidas técnicas, para...
Atrasos na liberação de produtos em portos e aeroportos continuam gerando prejuízos para empresas de diagnóstico in-vitro
Os constantes atrasos da Anvisa na liberação de produtos para saúde em portos e aeroportos do país foi o foco das discussões em reunião do grupo de Logística da CBDL, ocorrida na terça-feira, 11 de abril, no auditório da Dry Port, em Guarulhos. Segundo os...
Workshop promovido pela CBDL foi um sucesso de público
Com a presença dos mais conceituados profissionais do segmento laboratorial, o workshop “O Papel e o Futuro do Diagnóstico na Saúde Suplementar – Tendências” promovido pela Câmara Brasileira de Diagnóstico Laboratorial (CBDL), no último dia 30 de março, na sede do...
Critérios para importação de produtos que abastecem rede pública de saúde deve ser objeto de RDC da Anvisa
Expedida pela Anvisa, uma nova RDC (Resolução da Diretoria Colegiada) deverá ser objeto de Consulta Pública nos próximos dias. A proposta visa estabelecer critérios e procedimentos para a importação de produtos sujeitos à vigilância sanitária, sem registro no Brasil,...
